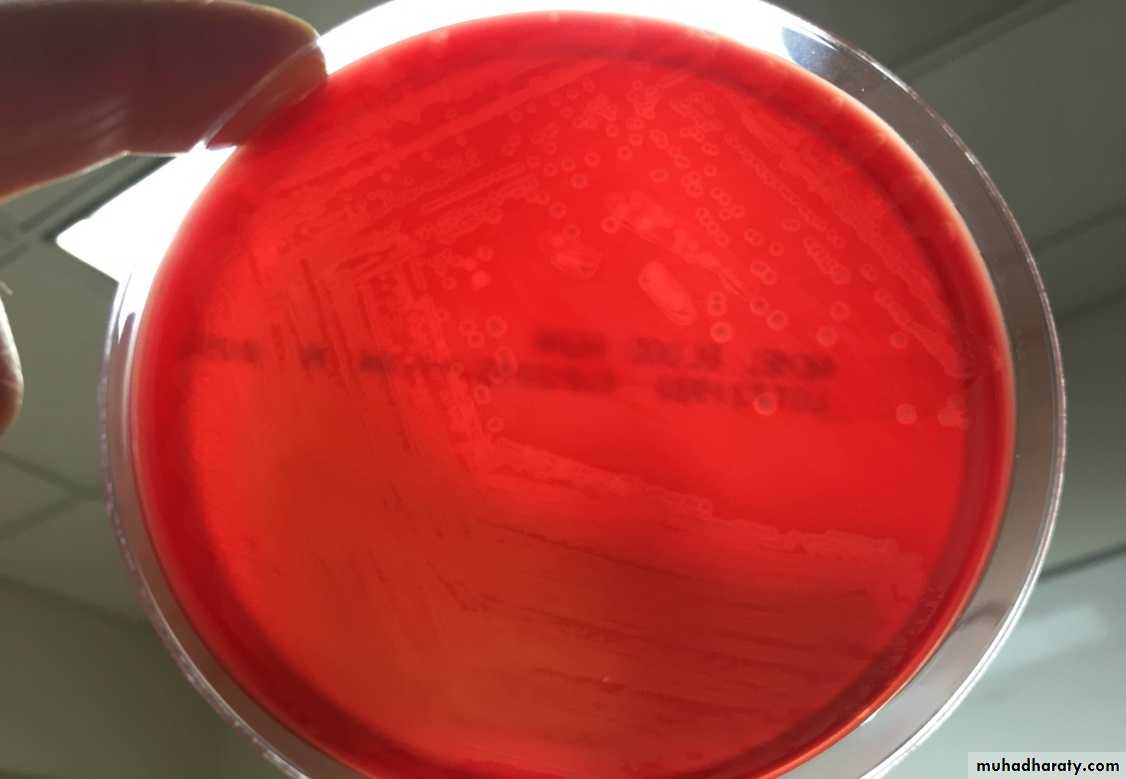

Listeria monocytogenes
There are several species in the genus Listeria.L monocytogenes is important as a cause of a wide spectrum of disease in animals and humans.
L monocytogenes can be growing and surviving over a wide range of environmental conditions.
It can survive at refrigerator temperatures (4°C), under conditions of low pH and high salt conditions.
Therefore, it is an important foodborne pathogen.
• According to the data from the Centers for Disease Control and Prevention indicate that foodborne listeriosis is declining. However, one of the largest and most deadly outbreaks of listeriosis in the United States (147 cases across 28 states and 33 deaths) by contaminated cantaloupe. This outbreak indicated the wide nature of this organism and its ability to easily contaminate a variety of foods during any stage of the food handling process.
Morphology and Identification
L monocytogenes is a short, G+, non–spore-forming rod. It is catalase positive andhas a tumbling end-over-end motility only at 22–28°C but not at 37°C;
the motility test rapidly differentiates Listeria from diphtheroids that are members of the normal flora of the skin.
L. monocytogenes
Culture and Growth Characteristics
Listeria grows on 5% sheep blood agar on which it exhibits the characteristic small zone of hemolysis around and under colonies.The organism is a facultative anaerobe and
is catalase positive, esculin hydrolysis positive, and motile.
Listeria produces acid but not gas from utilization of a variety of carbohydrates.
The motility at room temperature and hemolysin production are primary findings that help differentiate Listeria from coryneform bacteria.
Esculin hydrolysis test
L. monocytogenes in blood agarAntigenic Classification
Serologic classification is done only in reference laboratories and is primarily used for epidemiologic studies.There are 13 known serovars based on O (somatic) and H (flagellar) antigens. Serotypes 1/2a, 1/2b, and 4b make up more than 95% of the isolates from humans. Serotype 4b causes most of the foodborne outbreaks.
Pathogenesis
L monocytogenes enters the body through the gastrointestinal tract after eating of contaminated foods such as cheese, fruit, or vegetables.
1-The organism has several adhesin proteins (Ami, Fbp A, and flagellin proteins) that facilitate bacterial binding to the host cells and that contribute to virulence.
2-It has cell wall surface proteins called internalins A and B that interact with E-cadherin, a receptor on epithelial cells, promoting phagocytosis into the epithelial cells.
3-After phagocytosis, the bacterium is enclosed in a phagolysosome, where the low pH activates the bacterium to produce listeriolysin O.
3- listeriolysin O enzyme, with two phospholipases, lyses the membrane of the phagolysosome and allows the listeriae to escape into the cytoplasm of the epithelial cell.
4-The organisms proliferate, and ActA, another listerial surface protein, induces host cell actin polymerization, which propels them to the cell membrane. Pushing against the host cell membrane, they cause formation of elongated protrusions called filopods.
5-These filopods are ingested by next epithelial cells, macrophages, the listeriae are released, and the cycle begins again. L monocytogenes can move from cell to cell without being exposed to antibodies, complement, or polymorphonuclear cells.
6-Listeriae produce siderophores and are able to obtain iron from transferrin.
Clinical Findings
There are two forms of perinatal human listeriosis.Early onset syndrome (granulomatosis infantiseptica) is the result of infection in uterus and is a disseminated form of the disease characterized by sepsis, pustular lesions, and granulomas containing L monocytogenes in multiple organs. Death may occur before or after delivery.
The late-onset syndrome causes the development of meningitis between birth and the third week of life; it is often caused by serotype 4b and has a significant mortality rate.
Healthy persons exposed to L monocytogenes in food may not become ill or may develop a mild, self-limiting gastroenteritis lasting 1–3 days. This develops after an incubation period of 6–48 h.
Symptoms include fever, chills, headache, abdominal pain, and diarrhea.
Immunocompromised individuals can develop Listeria meningoencephalitis, bacteremia.
Many antimicrobial drugs inhibit Listeria species in vitro.
In vivo ampicillin, erythromycin, or intravenous trimethoprim–sulfamethoxazole.
Cephalosporins and fluoroquinolones are not active against L monocytogenes.
Ampicillin plus gentamicin is often recommended for therapy, but gentamicin does not enter host cells and may not help treat the Listeria infection.
Trimethoprim–sulfamethoxazole is the drug of choice for central nervous system infections in patients who are allergic to penicillin.